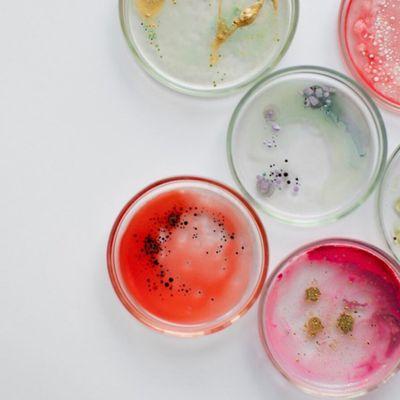
Best Natural Smile

Orly Hendizadeh, DDS
Closed
1260 15th St
Santa Monica, CA 90404
Located in the vibrant city of Santa Monica California you'll find the skilled services of Dr. Orly Hendizadeh who holds the esteemed title of D.D.S. (Doctor of Dental Surgery) specializing in General Dentistry. As a seasoned general dentist Dr. Hendizadeh is dedicated to providing top-notch dental care to patients of all ages in the Santa Monica area. With a focus on comprehensive oral health Dr. Orly Hendizadeh's practice offers a wide range of general dentistry services to ensure that each patient receives personalized care tailored to their unique needs. Whether it's a routine check-up preventive care or specific dental treatments Dr. Hendizadeh's expertise and commitment to excellence make them a trusted choice for maintaining a healthy and radiant smile in the Santa Monica community.
Generated from this place's public information
Also at this address
Find related places
See a problem?
You might also like
Partial Data by Foursquare.